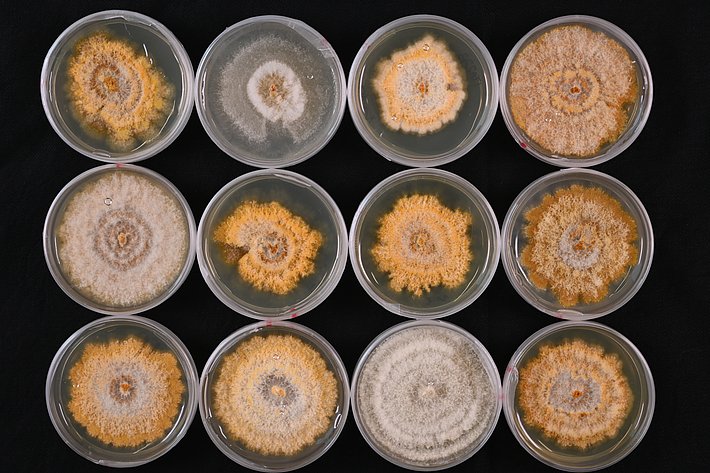
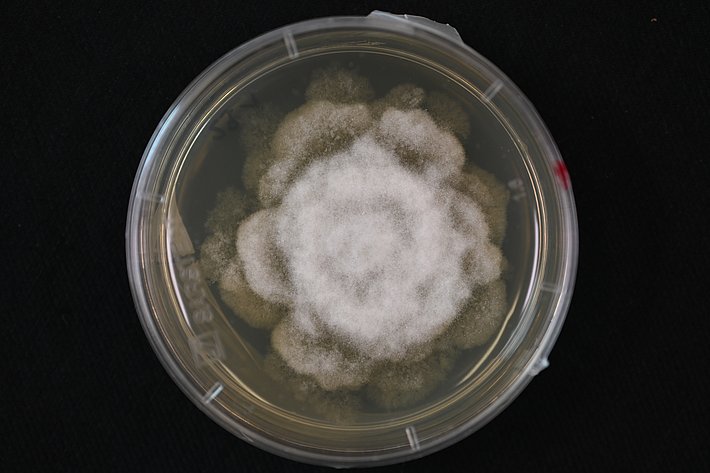

Image 3 of 20
Cankers caused by Cryphonectria parasitica (chestnut blight) in Murg SG.

Image 8 of 20
Petiole with fruiting bodies of Hymenoscyphus fraxineus (Ash die back) on an Ash leaf.

Image 18 of 20
Carolina on a short scientific mission in Palencia, Spain. Work with Fuasrium circinatum.

Image 19 of 20
Inoculation of Cryphonectria radicalis on wood blocks in the lab.